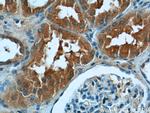
DNAH17 Antibody in Immunohistochemistry (Paraffin) (IHC (P))
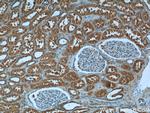
DNAH17 Antibody in Immunohistochemistry (Paraffin) (IHC (P))

Search
Proteintech
DNAH17 Polyclonal Antibody
{{$productOrderCtrl.translations['antibody.pdp.commerceCard.promotion.promotions']}}
{{$productOrderCtrl.translations['antibody.pdp.commerceCard.promotion.viewpromo']}}
{{$productOrderCtrl.translations['antibody.pdp.commerceCard.promotion.promocode']}}: {{promo.promoCode}} {{promo.promoTitle}} {{promo.promoDescription}}. {{$productOrderCtrl.translations['antibody.pdp.commerceCard.promotion.learnmore']}}
产品信息
24488-1-AP
种属反应
宿主/亚型
分类
类型
抗原
偶联物
形式
浓度
规格
纯化类型
保存液
内含物
保存条件
运输条件
产品详细信息
Immunogen sequence: MEQADFTML PTFIAKVLDT ICFIWATSEY YNTPARIIVI LQEFCNQIIE MTRTFLSPEE VLKGLQGEIE EVLSGISLAV NVLKELYQTY DFCCVNMKLF FKDKEPVPWE FPSSLAFSRI NSFFQRIQTI EELYKTAIEF LKLEKIELGG VRGNLLGSLV TRIYDEVFEL VKVFADCKYD PLDPGDSNFD RDYADFEIKI QDLDRRLATI FCQGFDDCSC IKSSAKLLYM CGGLMERPLI LAEVAPRYSV MLELFDAELD NAKILYDAQM AASEEGNIPL IHKNMPPVAG QLKWSLELQE RLEVSMKHLK HVEHPVMSGA EAKLTYQKYD EMMELLRCHR EKIYQQW (299-644 aa encoded by BC112284 )
靶标信息
Dyneins are microtubule-associated motor protein complexes composed of several heavy, light, and intermediate chains. DNAH17 is a heavy chain associated with axonemal dynein (Milisav and Affara, 1998 [PubMed 9545504]).[supplied by OMIM, Mar 2008].
仅用于科研。不用于诊断过程。未经明确授权不得转售。
生物信息学
蛋白别名: Axonemal beta dynein heavy chain 17; Axonemal dynein heavy chain-like protein 1; Ciliary dynein heavy chain 17; Ciliary dynein heavy chain-like protein 1; Dynein axonemal heavy chain 17; Dynein axonemal light chain 2; dynein heavy chain 17, axonemal; dynein light chain 2, axonemal; dynein, axonemal, heavy polypeptide 17; FLJ40457; unnamed protein product
基因别名: DNAH17; DNAHL1; DNEL2; SPGF39
UniProt ID: (Human) Q9UFH2
Entrez Gene ID: (Human) 8632